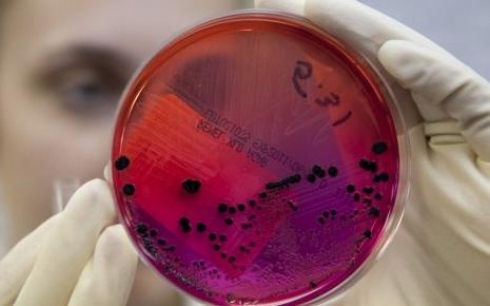

лента БЛОГЕРа
-
 В Карагандинской области владельцу покусавшей ребенка собаки грозит штраф
В Карагандинской области владельцу покусавшей ребенка собаки грозит штраф
Владельцу собаки, покусавшей четырехлетнего ребенка в Карагандинской области, грозит штраф в размере 21 210 тенге, передает Today.kz со ссылкой на пресс-службу ДВД региона. Мальчик был доставлен в больницу, где ему оказали медицинскую помощь и сделали прививки от бешенства.
-
 Собака покусала четырехлетнего ребенка в Карагандинской области
Собака покусала четырехлетнего ребенка в Карагандинской области
В центральную больницу Приозерска доставили четырехлетнего мальчика, которого искусала собака, передает корреспондент Today.kz со ссылкой на службу скорой помощи.
-
 Нарушитель натравил на полицейских разъяренного ротвейлера в Жезказгане
Нарушитель натравил на полицейских разъяренного ротвейлера в Жезказгане
Сотрудникам дорожно-патрульной службы Жезказгана пришлось применить табельное оружие для защиты от натравленной на них собаки, передает корреспондент Today.kz со ссылкой на информированный источник.
-
 Бесхозный скотомогильник нашли в селе Еркиндик
Бесхозный скотомогильник нашли в селе Еркиндик
В Карагандинской области найдено бесхозное захоронение животных, предположительно зараженное сибирской язвой. Об этом телеканалу "Астана" сообщил исполняющий обязанности руководителя Управления ветеринарии области Саят Мусин.
-
 В ТОО «Қарағанды Су» прокомментировали ситуацию с живыми червями в воде
Жительница Юго-Востока обратилась просьбой проинформировать население о том, что в холодной воде можно найти живых червей. Женщина живет в микрорайоне Степной-4."Вечером я набирала холо...
В ТОО «Қарағанды Су» прокомментировали ситуацию с живыми червями в воде
Жительница Юго-Востока обратилась просьбой проинформировать население о том, что в холодной воде можно найти живых червей. Женщина живет в микрорайоне Степной-4."Вечером я набирала холо...
-
 Выделенные на содержание скотомогильников миллионы бесследно пропали
Выделенные на содержание скотомогильников миллионы бесследно пропали
В Казахстане решили взять под контроль все возможные очаги сибирской язвы. Как выяснилось, на охрану заброшенных скотомогильников из бюджета выделялись колоссальные деньги, и очевидно, что далеко не все из них пошли по назначению, сообщает КТК.
-
 Компания «Натиже» заверила, что их продукция безопасна
23 июня посредством WhatsApp распространился слух о том, что не следует покупать продукцию компании «Натиже», так как она изготавливается из молока, собранного в Шетском районе К...
Компания «Натиже» заверила, что их продукция безопасна
23 июня посредством WhatsApp распространился слух о том, что не следует покупать продукцию компании «Натиже», так как она изготавливается из молока, собранного в Шетском районе К...
-
 Возникновение сибирской язвы в Шетском районе не связано со случаями в Восточно-Казахстанской области
Ответить на этот вопрос точно в Карагандинской областной территориальной инспекции Комитета ветеринарного контроля и надзора смогут только после всех проверок различными службами.- В Караган...
Возникновение сибирской язвы в Шетском районе не связано со случаями в Восточно-Казахстанской области
Ответить на этот вопрос точно в Карагандинской областной территориальной инспекции Комитета ветеринарного контроля и надзора смогут только после всех проверок различными службами.- В Караган...
-
В Караганде студент, который осматривал женщину, больную сибирской язвой, попал в больницу На сегодняшний день в стационаре находятся восемь больных. У семи из них лабораторно была подтверждена сибирская язва. В Управлении здравоохранения Карагандинской области сообщили, что состо...
-
 Компания «Натиже» заверила, что их продукция безопасна
23 июня посредством WhatsApp распространился слух о том, что не следует покупать продукцию компании «Натиже», так как она изготавливается из молока, собранного в Шетском районе К...
Компания «Натиже» заверила, что их продукция безопасна
23 июня посредством WhatsApp распространился слух о том, что не следует покупать продукцию компании «Натиже», так как она изготавливается из молока, собранного в Шетском районе К...
-
 Беби-бум в Карагандинском зоопарке
Беби-бум в Карагандинском зоопарке
Один их старейших зоологических парков страны сейчас переживает не самые хорошие времена. Однако на приплоде обитателей это никак не отражается, напротив, животные не устают удивлять и ставят необычные рекорды.
-
 Карагандинцы ответили, где выгуливают домашних питомцев
Карагандинцы ответили, где выгуливают домашних питомцев
Домашнее животное требует от хозяина не только ласки, но и ухода. Если питомец немалых размеров, то он нуждается еще и в своевременном и регулярном выгуле.
-
 Возбуждены два уголовных дела в связи с ситуацией с сибирской язвой в Карагандинской области
Возбуждены два уголовных дела в связи с ситуацией с сибирской язвой в Карагандинской области
Врачам сразу трех больниц вменяют уголовные статьи в связи с ситуацией с сибирской язвой в Карагандинской области, передает корреспондент Today.kz со ссылкой на акима региона Нурмухамбета Абдибекова. Под подозрение попали медики городской больницы №1, областных кожно-венерологического диспансера и медицинского центра.
-
 Семьям погибших от сибирской язвы выделено по 400 тысяч тенге
Семьям погибших от сибирской язвы выделено по 400 тысяч тенге
На совещании с участием премьер-министра Казахстана Карима Масимова в Караганде аким области Нурмухамбет Абдибеков пожаловался на нехватку ветеринарных специалистов в регионе, передает корреспондент Today.kz со ссылкой на пресс-службу акимата области.
-
 Масимов в Карагандинской области дал ряд поручений из-за вспышки сибирской язвы
Масимов в Карагандинской области дал ряд поручений из-за вспышки сибирской язвы
Карим Масимов прибыл с рабочей поездкой в Карагандинскую область. Об этом глава правительства сообщил в своем аккаунте в Twitter, передает Today.kz.
-
 Названы предварительные причины вспышки сибирской язвы в Казахстане
Названы предварительные причины вспышки сибирской язвы в Казахстане
Названы предварительные причины вспышки сибирской язвы в Карагандинской области, передает корреспондент Tengrinews.kz.
-
 Аким Карагандинской области провел сход жителей села Еркиндик
Аким Карагандинской области провел сход жителей села Еркиндик
Аким Карагандинской области Нурмухамбет Абдибеков провел сход жителей села Еркиндик Шетского района, где произошла вспышка сибирской язвы. Об этом сообщила пресс-служба главы региона.
-
 В Темиртау усилился контроль за продажей мяса
В Темиртау усилился контроль за продажей мяса
В связи с подозрением на сибирскую язву и введением карантина в селе Еркендык Шетского района в городе началась проверка мясных отделов и их поставщиков. Как заверяют наши врачи, в Темиртау эпидситуация под полным контролем.


 vk
vk facebook
facebook twitter
twitter ok
ok mail.ru
mail.ru instagram
instagram youtube
youtube
 Объявления
Объявления
 Погода
Погода Медиа
Медиа Справочник
Справочник